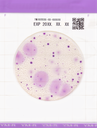
Easy Plate YMR

Easy Plate YMR
1x100 Placas/Paquete
Placa portátil lista y fácil de usar: no se requiere preparación de medio, lo que elimina el desperdicio de medio, así como el aparato de esterilización para preparar el medio.
La detección de colonias en placa es sencilla y clara. Listo para usar, coloque una suspensión de muestra en la placa y comience la incubación.
Se pueden aislar colonias individuales en la placa para realizar pruebas de identificación adicionales. Muy poco espacio de incubación y residuos reducidos
Autodifusible, preciso, Certificado (AOAC-PTM, NordVal, MicroVal), REDUCE el espacio, el tiempo y el desperdicio.
Con EasyPlate YMR se pueden diferenciar levaduras y mohos por el desarrollo del color. El medio contiene el sustrato enzimático cromogénico X-Phos, que se vuelve azul en muchas levaduras. Los mohos forman colonias esponjosas con un color característico. Los antibióticos inhiben el crecimiento de bacterias. EasyPlate YMR permite un muy buen crecimiento tridimensional de levaduras y mohos.EasyPlate YMR presentado para la certificación AOAC
Tiempo y temperatura de incubación: 48 - 72 a 25 - 30 °C
Vida útil: 12 meses después de la fabricación.
Almacenamiento: Temperatura ambiente (+ 1 a + 30 °C)
Pretratamiento de muestras
Recuento viable en agua o alimento líquido | Depositar 1 ml de muestra (diluir si es necesario) en el centro de EasyPlate YM-R
Recuento de microorganismos viables en alimentos sólidos |Añadir solución tampón a la muestra y homogeneizar con el Stomacher®. Verter 1 ml de muestra (diluir si es necesario) en el centro de la placa seca EasyPlate YM-R
Recuento de microorganismos viables en la muestra de prueba del hisopo | Utilice el hisopo para limpiar la superficie y colóquelo en el dispositivo con la solución limpiadora. Coloque 1 ml de solución limpiadora (diluya si es necesario) en el centro de la EasyPlate YM-R.
Instrucciones de prueba
Abra la tapa y coloque 1 ml de muestra en el centro del EasyPlate YM-R
La muestra se difunde de manera automática y uniforme en la hoja y transforma la hoja seca en un gel en cuestión de segundos.
Coloque nuevamente la tapa en la placa y escriba la información necesaria en la sección de memorando.
.
Después de la incubación, cuente la cantidad de colonias coloreadas debajo de la placa.
- Easy Plate YMR YM20260326A exp 25.09.2027.pdf
- Easy Plate YMR YM20260220A exp 19.08.2027.pdf
- Easy Plate YMR YM20260114A exp 13.07.2027.pdf
- Easy Plate YMR YM20260113A exp 12.07.2027.pdf
- Easy Plate YM20251107A exp 06.05.2027.pdf
- Easy Plate YM YM20251028A exp 27.04.2027.pdf
- Easy Plate YMR YM20250912A exp 11.03.2027.pdf
- Easy Plate YM20250717A exp 16.01.2027.pdf
- Easy Plate YMR YM20250331A exp 30.09.2026.pdf
- Easy Plate YMR YM20250328A exp 27.09.2026.pdf
- Easy Plate YMR YM20250130A exp 29.07.2026.pdf
- 61977_YM20241220A.pdf
- 61977_YM20241125A.pdf
- 61977_YM20241024A.pdf
- 61977_YM20241023A.pdf
- Easy Plate YM20241024A exp 23.04.26 .pdf
- Easy Plate YMR YM20240827A 26.02.2026.pdf
- Easy Plate YMR YM20240516A exp 15.11.2025.pdf
- Easy Plate YM-R - YM20240124A - exp 23.07.2025.pdf
- Easy Plate YM-R - YM20240123A - exp 22.07.2025.pdf
- Easy Plate YM-R - YM20231206A - exp 05.06.2025.pdf
- Easy Plate YM-R - YM20231205A - exp 04.06.2025.pdf
- Easy Plate YM-R - YM20230927A - exp 26.03.2025.pdf
- Easy Plate YM-R - YM20230901A - exp 28.02.2025.pdf
- Easy Plate YM-R - YM20230721A - exp 20.01.2025.pdf
- Easy Plate YM-R - YM20230627A - exp 26.12.2024.pdf
- Easy Plate YM-R - YM20230615A - exp 14.12.2024.pdf
- Easy Plate YM-R - YM20230615A - exp 14.12.2024 .pdf
- Easy Plate YM-R - YM20230614A - exp 13.12.2024.pdf
- Easy Plate YM-R - YM20230428A - exp 27-10-2024.pdf
- Easy Plate YM-R - YM20230316A - exp 15-09-2024 .pdf
- Easy Plate YM-R - YM20230214A - exp 13-08-2024.pdf